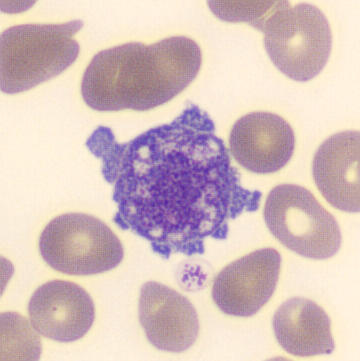
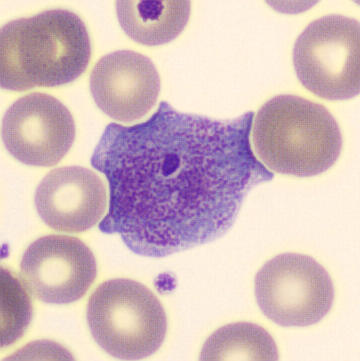

Trombocytair
Niets is zo divers als de natuur. In combinatie met externe factoren zoals infecties, maligne processen en de behandeling daarvan met immuunsuppressiva of chemotherapie, en mede beïnvloed door variaties in afname en analyse, kunnen sporadisch zeer unieke varianten van hematologische cellen worden waargenomen.
Onderstaande cellen zijn in de loop der jaren verzameld; voor veel van deze varianten geldt dat zij geen aanvullende diagnostische waarde hebben ten opzichte van de afwijkingen die reeds in het preparaat aanwezig waren.